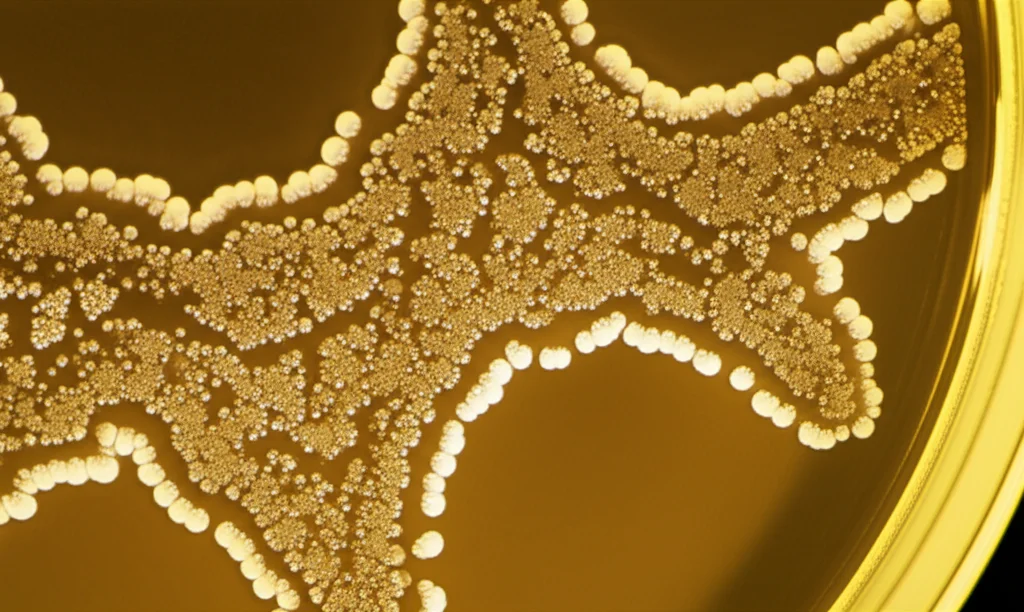
Microfotografia ad alta risoluzione di colonie batteriche di Thermoanaerobacter kivui su una piastra di Petri con terreno Gelrite, illuminazione controllata da laboratorio, obiettivo macro 100mm, messa a fuoco precisa sui bordi delle colonie.

Hi-TARGET: La Rivoluzione CRISPR per Modificare il Batterio “Mangia-CO2” T. kivui!
Ragazzi, oggi vi voglio parlare di una cosa che mi entusiasma un sacco: un nuovo strumento che abbiamo sviluppato per “giocare” con il DNA di un batterio davvero speciale, il Thermoanaerobacter kivui. Perché è speciale? Beh, immaginate un microrganismo che ama il caldo (è un termofilo, vive a temperature elevate) e che si nutre di CO2, CO e idrogeno (H2) per produrre energia e crescere velocemente. Capite bene che in un mondo che cerca disperatamente soluzioni per un’economia circolare del carbonio, avere un “campione” del genere è oro colato!
Questo batterio, T. kivui, potrebbe diventare una vera star della biotecnologia industriale. Pensate alla possibilità di usarlo per trasformare gas di scarico o C1 (molecole con un solo atomo di carbonio) in prodotti utili come etanolo, acetone, isopropanolo… roba che vale! Ma c’è un “ma”: per fargli produrre queste cose al posto del suo solito prodotto (principalmente acetato), dobbiamo “hackerare” il suo codice genetico, cioè fare ingegneria genetica. E qui casca l’asino, o meglio, cascava.
Il Vecchio Metodo? Lento e Macchinoso
Fino ad oggi, gli strumenti per modificare il genoma di T. kivui non erano il massimo. C’era un metodo basato su un gene chiamato pyrE, che funziona, per carità, ma è un processo lungo, laborioso, a volte inefficiente. Richiede un sacco di passaggi, selezioni, controlli… e a volte, dopo tutta la fatica, la modifica non riesce nemmeno o il batterio torna com’era prima. Insomma, non proprio l’ideale se vuoi sviluppare rapidamente ceppi batterici super performanti per l’industria. Serviva una svolta, qualcosa di più rapido, efficiente e versatile.
Ecco Hi-TARGET: Il CRISPR “Fatto in Casa” per T. kivui
Ed è qui che entriamo in gioco noi con Hi-TARGET! Cos’è? È un nuovo sistema di editing genetico basato su CRISPR, ma con una particolarità: sfrutta il sistema CRISPR endogeno di tipo I-B che T. kivui possiede già! Avete capito bene, usiamo le sue stesse “armi” di difesa immunitaria (che i batteri usano contro i virus) per modificare il suo DNA come vogliamo noi. Geniale, no?
Abbiamo studiato a fondo il sistema CRISPR nativo di T. kivui. Abbiamo identificato le sequenze “chiave”: i “direct repeats” (sequenze ripetute), gli “spacers” (le sequenze che guidano il sistema sul bersaglio) e soprattutto il PAM (Protospacer Adjacent Motif). Il PAM è come una piccola “etichetta” sul DNA che il sistema CRISPR deve riconoscere per sapere dove tagliare. Nel nostro caso, abbiamo scoperto che la sequenza PAM preferita è “CCM” (dove M può essere C o A). Trovare questo PAM è stato cruciale, ed è abbastanza comune nel genoma di T. kivui, il che significa che possiamo, in teoria, mirare a qualsiasi gene!
Migliorare l’Ingresso: Trasformazione Turbo!
Prima di poter usare Hi-TARGET, dovevamo risolvere un altro problema: far entrare il DNA esogeno (il nostro plasmide con le istruzioni per l’editing) dentro T. kivui. La trasformazione naturale di questo batterio non era molto efficiente. Abbiamo lavorato sodo per ottimizzare il protocollo. Abbiamo cambiato l’agente solidificante per le piastre (usando Gelrite invece del solito agar, che funziona meglio ad alte temperature), abbiamo ridotto il volume di semina e abbassato la temperatura durante la trasformazione e la crescita iniziale (da 66°C a 55°C, perché abbiamo notato che il plasmide era più stabile a temperature leggermente inferiori). Risultato? Un’efficienza di trasformazione aumentata di ben 245 volte! Mica male, eh? Ora abbiamo un modo robusto per introdurre il nostro “kit di modifica”.
Hi-TARGET alla Prova dei Fatti: Precisione Chirurgica
Con la trasformazione ottimizzata e il sistema Hi-TARGET pronto, siamo passati all’azione. Cosa abbiamo fatto? Praticamente di tutto!
- Gene Knock-out (Eliminazione): Abbiamo dimostrato che Hi-TARGET può eliminare geni specifici con un’efficienza del 100%! Abbiamo “spento” tre geni diversi: pyrE (come prova di concetto), rexA (un regolatore metabolico) e hrcA (coinvolto nella risposta allo stress da calore). Efficienza perfetta, ogni volta.
- Gene Knock-in (Inserimento): Non solo eliminare, ma anche inserire! Abbiamo integrato con successo il gene per una proteina fluorescente (pFAST) al posto del gene della lattato deidrogenasi (ldh). Anche qui, 100% di successo nell’integrazione. Questo apre le porte all’inserimento di interi pathway metabolici per produrre nuove molecole.
- Mutazioni Puntiformi (Modifica di Singole Lettere): Questa è spesso la sfida più difficile per l’editing genetico. Abbiamo provato a introdurre una specifica mutazione puntiforme nel gene polC (che codifica per una DNA polimerasi). L’obiettivo era creare un ceppo “ipermutatore” per accelerare l’evoluzione adattativa in laboratorio. Anche se non abbiamo ottenuto l’ipermutazione desiderata (anzi, la mutazione ha leggermente ridotto il tasso di mutazione), abbiamo raggiunto un’efficienza di editing del 49% per questa singola modifica! Un risultato notevole rispetto ad altri sistemi in batteri simili.
- Gene Knock-down (Riduzione dell’Espressione): A volte non vuoi eliminare completamente un gene, magari perché è essenziale, ma solo ridurne l’attività. Abbiamo dimostrato che Hi-TARGET può fare anche questo (CRISPR interference o CRISPRi). Usando dei crRNA (le molecole guida) più corti del normale (11, 15, 20 basi invece di 36), siamo riusciti a ridurre l’espressione della proteina fluorescente pFAST integrata nel genoma fino al 52%. Più corto era il crRNA, maggiore la riduzione. Questo è utilissimo per studiare geni essenziali o per regolare finemente i pathway metabolici.
Scoperte Collaterali: Il Ruolo di rexA
Eliminando il gene rexA, abbiamo anche imparato qualcosa di nuovo sul metabolismo di T. kivui. Abbiamo visto che, in assenza di RexA, l’espressione del gene ldh (lattato deidrogenasi) aumenta significativamente. Analizzando il genoma, abbiamo trovato un sito di legame per RexA proprio vicino al gene ldh. Questo suggerisce fortemente che RexA agisca come un repressore per ldh, probabilmente in risposta allo stato redox della cellula (il rapporto NADH/NAD+). Una piccola scoperta resa possibile dalla precisione di Hi-TARGET.

Veloce è Meglio: Addio E. coli (se vuoi) e Curing Rapido
Una delle cose più fiche di Hi-TARGET è la sua velocità. Dall’inizio (preparazione del DNA) all’ottenimento di un ceppo modificato e “pulito” (senza il plasmide di editing) possono bastare solo 12 giorni! Questo è un passo avanti enorme rispetto ai metodi precedenti.
Come facciamo ad essere così veloci? In parte grazie all’efficienza del 100% per KO e KI, ma anche grazie a due trucchi:
- Editing Diretto dalla Miscela di Clonaggio: Abbiamo scoperto che non è nemmeno strettamente necessario clonare il plasmide di editing nel solito batterio ospite intermedio, E. coli (un processo che può essere lungo e a volte problematico). Possiamo prendere la miscela di DNA risultante dall’assemblaggio in vitro (usando una tecnica chiamata Golden Gate) e trasformarla direttamente in T. kivui. Funziona! L’efficienza è un po’ più bassa rispetto all’uso del plasmide purificato, ma comunque sufficiente e fa risparmiare un sacco di tempo.
- Curing Ottimizzato: Dopo aver fatto la modifica, è importante eliminare il plasmide che porta il sistema CRISPR, per evitare effetti indesiderati e per poter fare ulteriori modifiche in futuro. Abbiamo sviluppato un protocollo di “curing” efficace. Semplicemente coltivando le cellule modificate a 66°C (la loro temperatura ottimale, ma a cui il plasmide è meno stabile) senza antibiotico, il plasmide si perde rapidamente. Abbiamo anche notato che usare bracci di omologia più corti (500 bp invece di 1000 bp) nel costrutto di editing non solo funziona benissimo (sempre 100% efficienza), ma accelera anche drasticamente il processo di curing (bastano circa 9 generazioni invece di 22).
Il Futuro è Adesso con Hi-TARGET
Insomma, Hi-TARGET è uno strumento potente, veloce, efficiente e versatile per l’ingegneria genetica di Thermoanaerobacter kivui. Permette di fare delezioni, inserzioni, mutazioni puntiformi e persino knock-down genico con una facilità e una rapidità impensabili prima.
Questo apre porte enormi. Possiamo finalmente studiare a fondo la fisiologia e il metabolismo affascinante di questo acetogeno termofilo. E, cosa forse ancora più importante, possiamo accelerare lo sviluppo di ceppi industriali di T. kivui capaci di produrre biocarburanti e prodotti chimici sostenibili a partire da fonti di carbonio rinnovabili o di scarto, contribuendo a un futuro più verde. Il lavoro è appena iniziato, ma con Hi-TARGET abbiamo messo il turbo alla ricerca!

Fonte: Springer
